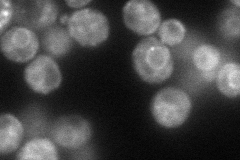
YDL122W
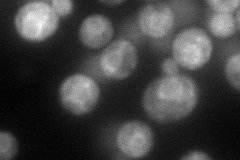
YDL122W
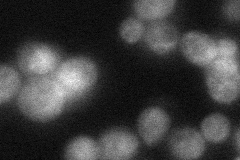
YDL122W
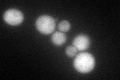
YDL122W
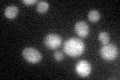
YDL122W

View description
Ubiquitin-specific protease that removes ubiquitin from ubiquitinated proteins; cleaves at the C terminus of ubiquitin fusions irrespective of their size; capable of cleaving polyubiquitin chains
Localization:
Intensity:
Fold change:
Significance:
-
C’ GFP library in SD

cytosol59.69 -
N' NOP1pr-GFP in SD
ER81.9837 -
N' TEF2pr-mCherry in SD
ER84.05 -
N' NATIVEpr-GFP in SD
ER29.3484 -
N' TEF2pr-VC and Cyto-VN in SD

below threshold26.3416 -
C’ GFP library in SD+DTT
cytosol61.641.03No -
C’ GFP library in SD+H2O2

cytosol65.921.1No -
C’ GFP library in Starvation Media
cytosol50.380.84No -
C’ GFP library on the background of Pup2-DaMP

cytosol -
C’ GFP library on the background of CCT mutant

cytosol64.11331.07397No
